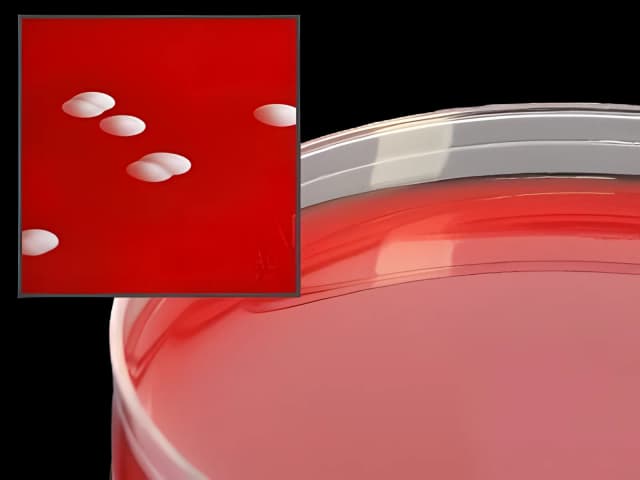
Prepared Media Phenylethyl Alcohol Agar with 5% Sheep Blood Mono-Plate Format

Prepared Media Phenylethyl Alcohol Agar with 5% Sheep Blood Mono-Plate Format
USAMP#98058394SKU: A93



Product Spotlight
- PEA (Phenylethyl Alcohol Agar) with 5% Sheep Blood, for gram positives, 15 x 100 mm plate, 18 mL fill
Enter a SKU ID to quickly find and add items to your cart